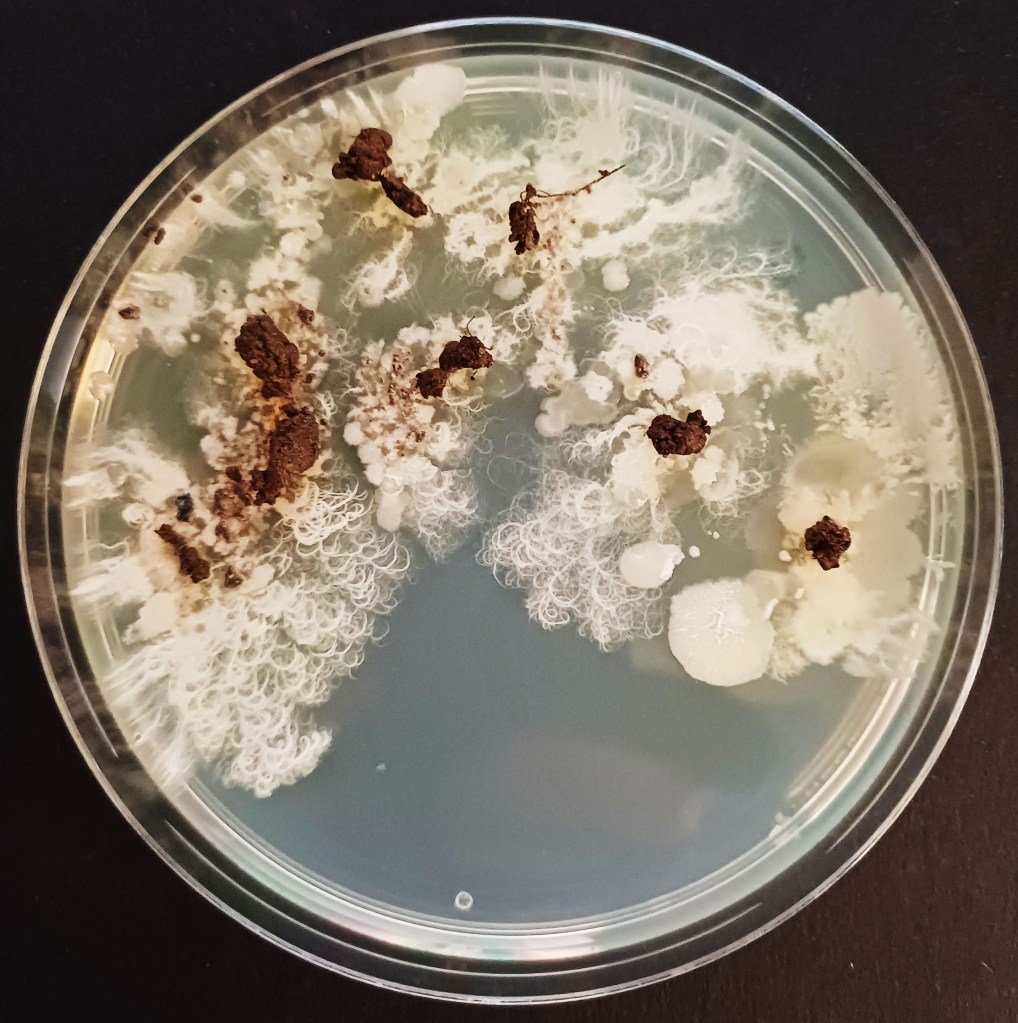
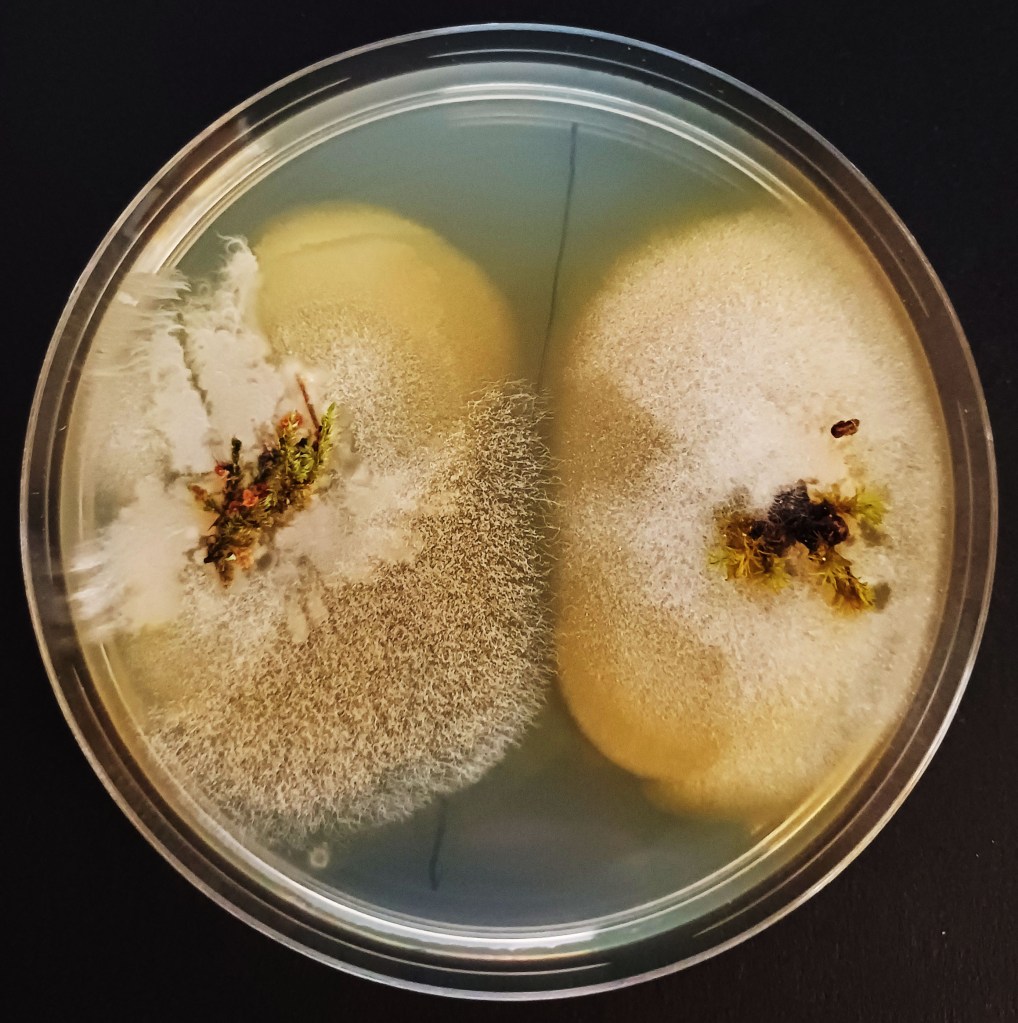
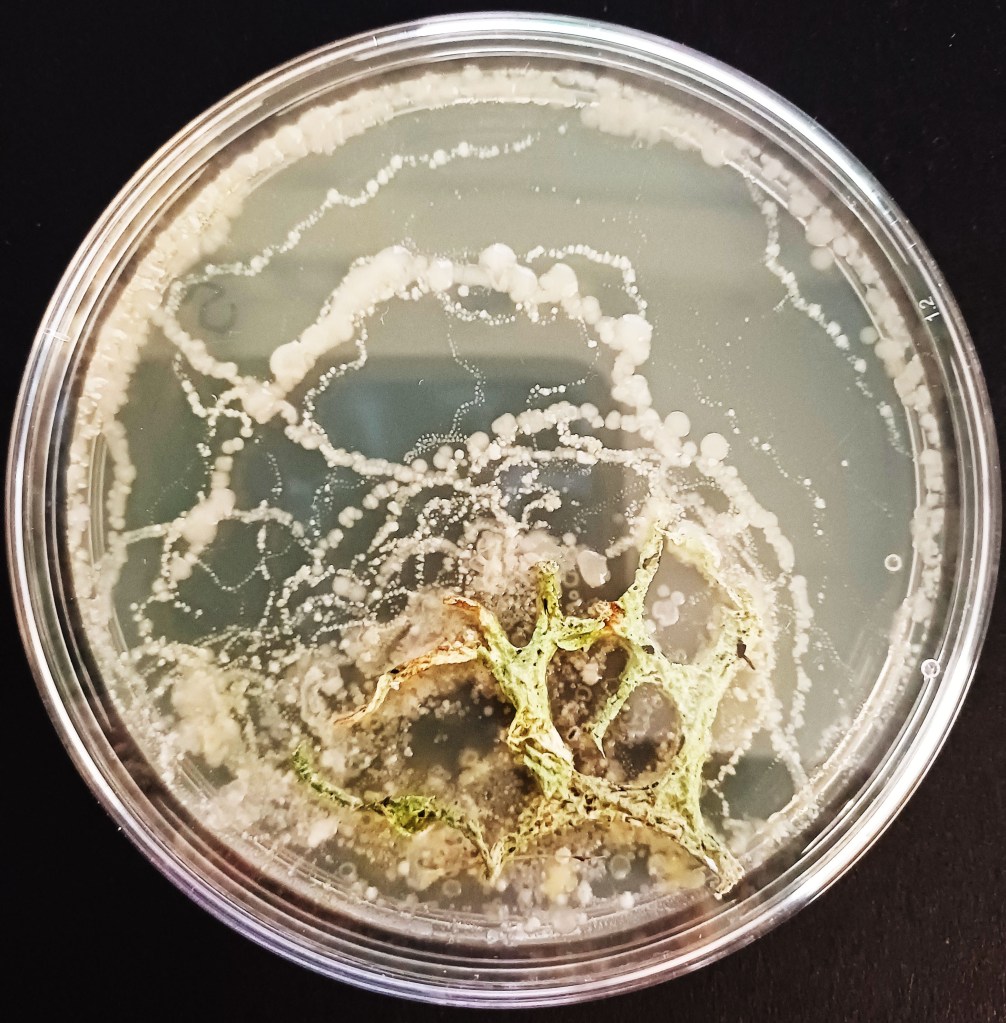
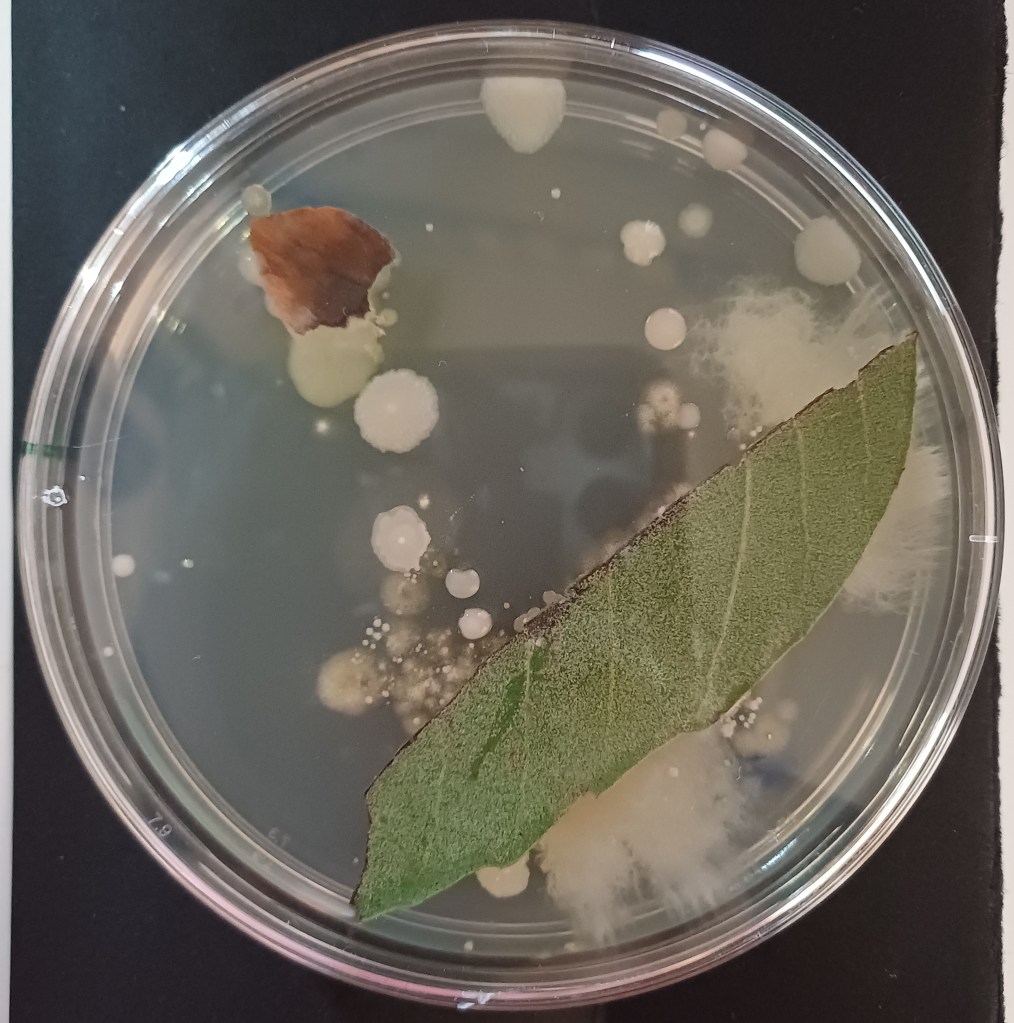

Strange Worlds 1 was a month long exhibition held in Dundee Botanics Green Gallery in May of 2025, timed to coincide with the ‘Plant Power’ event they held on Saturday 17th May. It featured a collection of prints I’d made using imagery from soil samples grown on agar plates.
I’d collected a series of samples of soil and other interesting bits from around the Botanics over a period of about 6 months from October 2024 – March 2025. Samples included, but were not limited to, soil from the roots of a tree that had fallen the night before in a storm, soil from near the roots of the Egyptian Papyrus in the glasshouses, and a small piece of lichen that had ended up on the ground after presumably falling from a tree branch. I tried to get a good variation in the samples from location of origin, to weather conditions leading up to collection and time of year.

Some of the plates and microscopy images.
I took my little samples back to the lab and grew them up on agar plates (standard LB Agar at room temperature) for a few days, depending on the speed of growth of anything interesting and where the weekend fell (no access on weekends). I took pictures of the whole plates on my phone, and pictures of interesting growth under the microscope, from 8x magnification to around 30x magnification. There were some really interesting and beautiful patterns!
I selected a few of these to work with in my grand scheme to produce screenprints of alien worlds. (It was not a grand scheme). The idea was to illustrate to people how beautiful and complex the unseen microscopic world of flora, fauna and fungi that make up the soil beneath our feet is. It is absolutely vital to life, but most people never think about it, and when its discussed, they tend to get the ‘ick’ face on. (I learned a word more recently that sums this up ‘Ecophobia’ this becomes more important as the PhD moves on).
Armed with what I’d learned about screen printing from my Masters, I went off down the Dundee Contemporary Arts (DCA) print studio and got to work producing 9 ‘Strange Worlds’ and 2 ‘views from a Strange World’. I played with fun colours, and had a shot with monochrome, I really enjoyed myself!






My favourite piece, storywise anyway, is the pink one. It’s of the whole plate that I’d set the little piece of fallen lichen on. This was one that ended up being left a little longer due to the weekend.
When I first took the pictures of the whole plate on my phone, I didn’t realise what I was looking at (largest plate image above). Under the microscope you just see small portions of the whole plate, so it wasn’t immediately obvious either. It was only when I started to look at my photos up close on my laptop that I realised that I was looking at footprints! Tiny trails of footprints picked out on the agar in increasingly small bacterial colonies! They told a story of a very small accidental captive, a tiny beetle that had been hiding in my lichen. The footprints were evidence of her exploration of the plate, larger colonies, not immediately recognisable as footprints dotted around the edge of the plate as the beetle explored the perimeter – testing the fences- getting smaller as the beetle explored further into and across the plate. The colonies of bacteria grown from the foorprints were getting smaller as the bacteria from the beetles feet got left behind on the agar, a bit like muddy footprints across a clean floor. Less bacteria = smaller colonies = clearer footprints. An accidental visitor to the strange world of the lab.
Sadly, by the time I’d realised what had happened it was too late to save the beetle. I was much more careful after this when collecting samples. I felt very guilty about the casualty of my art.
I set up the exhibition with some soil samples, and soil chromatographs and an extremely old microscope my Dad had found in his attic for context. I had some limited edition prints, some postcards and some pencil cases from my Masters available for sale (still available on all fronts as of time of writing – drop me an email if you’re interested!) And most importantly we had a lovely picnic opening to the exhibition! Thank you lovely people who came!








The Botanics ‘Plant Power’ event was a family fun day with a plant sciences theme that happened on Saturday 17th May. It was lots of fun and very well attended from what I could see. I opened up the gallery, put pens and paper all over the floor and invited children to imagine and draw the creatures that might live on my Strange Worlds, before heading out with a parent or guardian to collect a very specifically teaspoon sized sample of soil from their favourite part of the garden.

The image on the right indicates that at least my child and her bestie reinterpreted my instructions about ‘soil’. I took all the samples back to the lab and diligently plated them up, grew them for 5 days and photographed them. I then emailed the photos back to the relevant parental email addresses collected on the day with a very short survey. Just 2 simple questions. Not one single person replied to me. That was my first experience with post-workshop surveys.